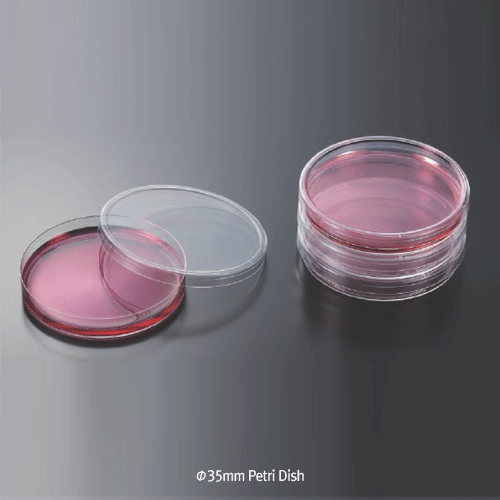
Daihan Science Φ35mm Disposable Mini Sterile Petri Dish, PS, Gas Exchangeable, 2-types of h10 &

Daihan Science Φ35mm Disposable Mini Sterile Petri Dish, PS, Gas Exchangeable, 2-types of h10 &
상품 한눈에 보기
고품질 PS 재질의 Φ35mm 일회용 미니 멸균 페트리디쉬로 균 배양, 시료 분리 및 저장에 적합. 매끄럽고 투명한 표면, 효과적인 가스 교환, ISO 및 CE 인증 생산. 10mm 및 15mm 두 가지 높이 타입 제공.
브랜드: Daihan Science
✨AI 추천 연관 상품
AI가 분석한 이 상품과 연관된 추천 상품들을 확인해보세요
연관 상품을 찾고 있습니다...
Φ35mm Disposable Mini Sterile Petri Dish, PS, Gas Exchangeable
2-types of h10 & h15mm
With Smooth & Glassy Clear Surface, γ-Sterile, 일회용 미니 멸균 페트리디쉬
- Made of top-quality Polystyrene (PS)
- Ideal for bacterial culture, sample separation, pre-treatment, and storage
- Smooth, striation-free surface for maximum usable area and distortion-free bottom
- Easy and secure stacking
- Very effective gas exchange
(1) Biofil® 10mm Height-type
- Manufactured in Class 100,000 cleanroom
- Materials conform to USP CLASS VI standards
- Quality controlled under ISO 13485 & 9001 and CE certification
- Batch certifications with Lot No. printed on every case for traceability
| Code | Description | Pk. | Price (₩) | Cs. | Price (₩) |
|---|---|---|---|---|---|
| J1.D000.035 | Petri Dish, PS, Sterile, Φ35×h10mm, 10pcs / Inner Pack | 10ea | 96pk |
(2) medclin® 15mm Height-type 🆕
| Code | Description | Pk. | Price (₩) | Cs. | Price (₩) |
|---|---|---|---|---|---|
| DM.Dis3004 | Petri Dish, PS, Sterile, Φ35×h15mm, 10pcs / Inner Pack | 10ea | 230pk |
Additional Information:
- Φ35mm Petri Dish
제품 이미지

🏷️Daihan Science 상품 둘러보기
동일 브랜드의 다른 상품들을 확인해보세요

Daihan Science
Daihan Science Kartell SAN Flow Indicator and PP Non-Return ValveFor Liquids or Gases, [ Italy
35,320원

Daihan Science
Daihan Science 휴마시스 심장질환, 임신/배란진단 체외진단키트
2,250원

Daihan Science
Daihan Science Φ35mm Disposable Mini Sterile Petri Dish, PS, Gas Exchangeable, 2-types of h10 &
1,740원

Daihan Science
Daihan Science DAIHAN Φ60~Φ150mm Sterile Disposable Petri Dish, E-beam or EO Gas Sterile<br>Ma
1,230원

Daihan Science
Daihan Science Keumsung 100% Cotton Lab Coat/Gown, General PurposeIdeal for Laboratory & Medic
34,220원
배송/결제/교환/반품 안내
배송 정보
| 기본 배송비 |
| 교환/반품 배송비 |
|
|---|---|---|---|
| 착불 배송비 |
| ||
| 교환/반품 배송비 |
| ||
결제 및 환불 안내
| 결제수단 |
|
|---|---|
| 취소 |
|
| 반품 |
|
| 환급 |
|
교환 및 반품 접수
| 교환 및 반품 접수 기한 |
|
|---|---|
| 교환 및 반품 접수가 가능한 경우 |
|
| 교환 및 반품 접수가 불가능한 경우 |
|
교환 및 반품 신청
| 교환 절차 |
|
|---|---|
| 반품 절차 |
|
문의 0
로그인 후 문의를 할 수 있습니다.